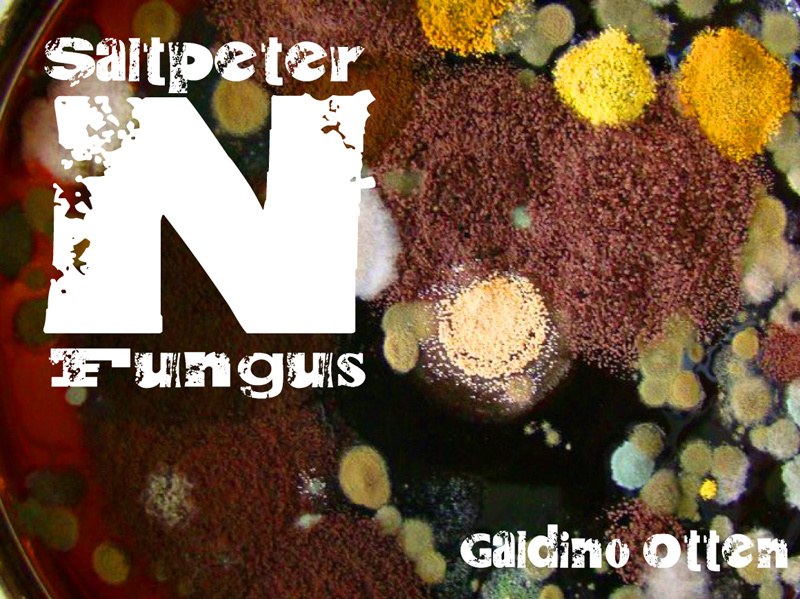

Saltpeter N Fungus Bold
TrueTypeZum persönlichen Gebrauch
- Akzente (teilweise)
- Euro
Saltpeter N Fungus.ttf
Zeichentabelle
Benutzen Sie bitte das Pull-Down Menü um verschiedene Zeichentabellen, die in dieser Schriftart enthalten sind, zu sehen.

Standard Schriftarten Information
Urheberrechte
Copyright (c) Galdino Otten, 2012
Schriftfamilie
Saltpeter N Fungus
Schriftunterfamilie
Fett
Einzigartige Unterfamilieidentifikation
Saltpeter N Fungus Bold:Version 1.00
Vollständiger Schriftname
Saltpeter N Fungus Bold
Name-Tabelle Version
Version 1.00 September 8, 2012, initial release
Postscript-Schriftbezeichnung
SaltpeterNFungus-Bold
Schutzmarken
Copyright (c) Galdino Otten, 2012
Designer
Galdino Otten
Beschreibung
This font was created using FontCreator 6.5 from High-Logic.com
Lizenz
Comic Gibi™ Font Family
By Galdino Otten © (copyright) Free for personal use
Donation required for Commercial Use
Email galdinocartum@gmail.com
Donate to Galdino Otten at PayPal.com
to galdinocartum@gmail.com
Blog:
http://onlyillustration.blogspot.com/
http://galdinoottenbr.blogspot.com/
Terms of Use/End User Lisence Agreement
Upon downloading this font the user bound to abide
the Free Font Terms of Use/Free Font End User
License Agreement (TOU/EULA) defined below.
This agreement pertains to you/the user and the
liscencing rights aquired with this download. These
rights are specific to free download and usage of this
font, i.e. a personal use License agreement.
-----------------------------------------------
Free Font Terms of Use
Free Font End User License Agreement:
-----------------------------------------------
1.) This font is free for personal use.
2.) The distribution of this font for financial gain or
profit is not permitted under any circumstances and is
strictly prohibited. Do not add this font to a font CD or
compilation and or archive that is to be sold for a profit.
Basically, don't sell this font, and do not make things
that are to be sold with this font... It's free for personal
use only. Commercial use requires the user to obtain a
Commercial Font End User License. A Commercial Font
End User License is granted after a PayPal donation has
been received. contact me galdinojp@yahoo.com.br
for
more details.
For profit scrapbooking and digital scrapbooking material (s) or
scrapbooking and digital scrapbooking material(s) intended to
be sold/resold with this font are also prohibited under this license,
and require a commercial License. To obtain a Commercial
Font End User License for this font contact me galdinojp@yahoo.com.br
Please note, scrapbooking and digital scrapbooking use of this
font is only restricted when pertaining to the making of any for
profit items. Otherwise creating items to be used "personally,"
whether in a traditional scrapbook or digital scrapbook is entirely
permitted under this free License.
3.) This font file must be kept intact as downloaded. Under no
circumstances may this font file itself be edited, altered, or modified
at any time or in any measure. This prohibits and indcludes but is
not limited to, renaming this font file, as well as the creation of
so-called "new" and/or derivitave fonts from this font file or any
other possible digital representations.
4.) Redistribution of this font is permitted only if this readme is, as well
as the font file itself, kept intact as is, and it is offered free of charge,
no fee is implemented upon the aquistition of this font. If you do
redistribute this font, please contact me galdinojp@yahoo.com.br with details.
5.) Upon downloading this font, the user accepts all liability and
sole responsibility for the font file and any accompanying files
therein. Galdino Otten is not responsible or
liable for any damages, loss or other consequences incurred
as a result of downloading this font, or otherwise relating or
associated with the download.
*Personal use does not constitute "public domain."
**If you are interested in the commercial use of this font or using
this font in any manner outside the realm of "personal use," you
must obtain the rights to use this font commercially
(Commercial Font End User License) prior to doing so. To obtain
a Commercial Font End User License Agreement with this font,
contact me galdinojp@yahoo.com.br
Thanks for accepting these terms.
By Galdino Otten © (copyright) Free for personal use
Donation required for Commercial Use
Email galdinocartum@gmail.com
Donate to Galdino Otten at PayPal.com
to galdinocartum@gmail.com
Blog:
http://onlyillustration.blogspot.com/
http://galdinoottenbr.blogspot.com/
Terms of Use/End User Lisence Agreement
Upon downloading this font the user bound to abide
the Free Font Terms of Use/Free Font End User
License Agreement (TOU/EULA) defined below.
This agreement pertains to you/the user and the
liscencing rights aquired with this download. These
rights are specific to free download and usage of this
font, i.e. a personal use License agreement.
-----------------------------------------------
Free Font Terms of Use
Free Font End User License Agreement:
-----------------------------------------------
1.) This font is free for personal use.
2.) The distribution of this font for financial gain or
profit is not permitted under any circumstances and is
strictly prohibited. Do not add this font to a font CD or
compilation and or archive that is to be sold for a profit.
Basically, don't sell this font, and do not make things
that are to be sold with this font... It's free for personal
use only. Commercial use requires the user to obtain a
Commercial Font End User License. A Commercial Font
End User License is granted after a PayPal donation has
been received. contact me galdinojp@yahoo.com.br
for
more details.
For profit scrapbooking and digital scrapbooking material (s) or
scrapbooking and digital scrapbooking material(s) intended to
be sold/resold with this font are also prohibited under this license,
and require a commercial License. To obtain a Commercial
Font End User License for this font contact me galdinojp@yahoo.com.br
Please note, scrapbooking and digital scrapbooking use of this
font is only restricted when pertaining to the making of any for
profit items. Otherwise creating items to be used "personally,"
whether in a traditional scrapbook or digital scrapbook is entirely
permitted under this free License.
3.) This font file must be kept intact as downloaded. Under no
circumstances may this font file itself be edited, altered, or modified
at any time or in any measure. This prohibits and indcludes but is
not limited to, renaming this font file, as well as the creation of
so-called "new" and/or derivitave fonts from this font file or any
other possible digital representations.
4.) Redistribution of this font is permitted only if this readme is, as well
as the font file itself, kept intact as is, and it is offered free of charge,
no fee is implemented upon the aquistition of this font. If you do
redistribute this font, please contact me galdinojp@yahoo.com.br with details.
5.) Upon downloading this font, the user accepts all liability and
sole responsibility for the font file and any accompanying files
therein. Galdino Otten is not responsible or
liable for any damages, loss or other consequences incurred
as a result of downloading this font, or otherwise relating or
associated with the download.
*Personal use does not constitute "public domain."
**If you are interested in the commercial use of this font or using
this font in any manner outside the realm of "personal use," you
must obtain the rights to use this font commercially
(Commercial Font End User License) prior to doing so. To obtain
a Commercial Font End User License Agreement with this font,
contact me galdinojp@yahoo.com.br
Thanks for accepting these terms.
Erweiterte Schriftarten Information
Unterstützte Plattformen
PlattformKodierung
UnicodeUnicode 2.0 und nachfolgende Semantik, nur BMP-Unicode
MacintoshWestliche (römische)
MicrosoftNur BMP Unicode
Schriftdetails
Kreiert2010-02-02
Änderung1
Zeichenzahl202
Einheiten pro Em2048
Einbindungs RechteEinbindung für Bearbeiten zulässig
Familien GattungOhne Klassifikation
StärkeFett
BreiteBreit
Mac StyleKursiv
RichtungNur stark von Links nach Rechts gehende Schriftzeichen
Muster BeschaffenheitRegelmäßig
AbstandUngleicher Abstand
Komplettes Paket enthält 2 unten aufgeführte Schriftarten:
Saltpeter N Fungus.ttf
Saltpeter N Fungus.ttf
Saltpeter N Fungus.ttf
Saltpeter N Fungus
TrueTypeFreeware